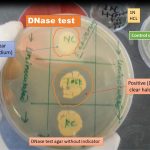
DNase test agar

Tag: procedure
MacConkey Medium: Introduction, Principle, Composition, Preparation, Procedure, Colony Morphology and Uses
 Introduction of MacConkey Medium MacConkey agar(MAC) or MacConkey Medium uses for...
Introduction of MacConkey Medium MacConkey agar(MAC) or MacConkey Medium uses for...
PAS Stain: Introduction, Principle, Procedure, Result Interpretation
 Introduction of Periodic acid Schiff’s (PAS) Stain PAS stain is...
Introduction of Periodic acid Schiff’s (PAS) Stain PAS stain is...
DNase Test: Introduction, Principle, Procedure, Result Interpretations and Limitations
Introduction of DNase test DNase test is useful for presumptive...
Introduction of DNase test DNase test is useful for presumptive...
